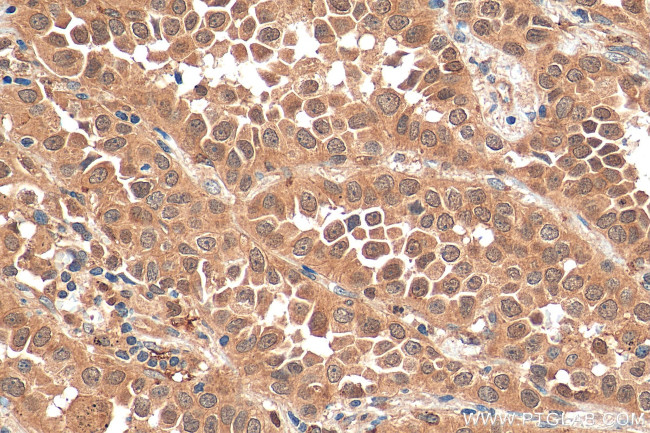
OCT4 Antibody in Immunohistochemistry (Paraffin) (IHC (P))

Search
Proteintech
OCT4 Polyclonal Antibody
{{$productOrderCtrl.translations['antibody.pdp.commerceCard.promotion.promotions']}}
{{$productOrderCtrl.translations['antibody.pdp.commerceCard.promotion.viewpromo']}}
{{$productOrderCtrl.translations['antibody.pdp.commerceCard.promotion.promocode']}}: {{promo.promoCode}} {{promo.promoTitle}} {{promo.promoDescription}}. {{$productOrderCtrl.translations['antibody.pdp.commerceCard.promotion.learnmore']}}
产品信息
11263-1-AP
种属反应
已发表种属
宿主/亚型
分类
类型
抗原
偶联物
形式
浓度
规格
纯化类型
保存液
内含物
保存条件
运输条件
产品详细信息
Immunogen sequence: MCKLRPLLQ KWVEEADNNE NLQEICKAET LVQARKRKRT SIENRVRGNL ENLFLQCPKP TLQQISHIAQ QLGLEKDVVR VWFCNRRQKG KRSSSDYAQR EDFEAAGSPF SGGPVSFPLA PGPHFGTPGY GSPHFTALYS SVPFPEGEAF PPVSVTTLGS PMHSN (102-265 aa encoded by BC020712)
靶标信息
POU5F1, also commonly known as Oct-4, is a maternally expressed octamer-binding protein that was the first transcription factor described for the early stages of development. The role of POU5F1 in embryonic development suggested that it might be useful in the creation of stem cells that might be useful in cell replacement therapies in the treatment of several degenerative diseases. Artificial stem cells, termed induced pluripotent stem (iPS) cells, can be created by expressing POU5F1 and the transcription factors Sox2, Klf4 and Lin28 along with c-Myc in mouse fibroblasts. More recently, experiments have demonstrated that iPS cells could be generated using expression plasmids expressing POU5F1, Sox2, KlfF4 and c-Myc, eliminating the need for virus introduction, thereby addressing a safety concern for potential use of iPS cells in regenerative medicine.
仅用于科研。不用于诊断过程。未经明确授权不得转售。
生物信息学
蛋白别名: 3-Oct; 4-Oct; DADB-104B20.2; gp-9; HGNC:9221; MGC22487; NF-A3; Oct-3; Oct-4; OCT4-B1; OCT4B-variant 2; Octamer-binding protein 3; Octamer-binding protein 4; Octamer-binding transcription factor 3; OTF-3; OTTHUMP00000221150; OTTHUMP00000221151; POU class 5 homeobox 1; POU domain transcription factor OCT4; POU domain, class 5, transcription factor 1; pou-2; POU-type homeodomain-containing DNA-binding protein; pou2; transcriptional regulator
基因别名: NF-A3; Oct-3; Oct-3/4; Oct-4; OCT3; Oct3/4; OCT4; OCT4Borf1; OTF-3; Otf-4; OTF3; Otf3-rs7; Otf3g; OTF4; POU5F1
UniProt ID: (Human) Q01860, (Mouse) P20263
Entrez Gene ID: (Human) 5460, (Mouse) 18999, (Rat) 294562